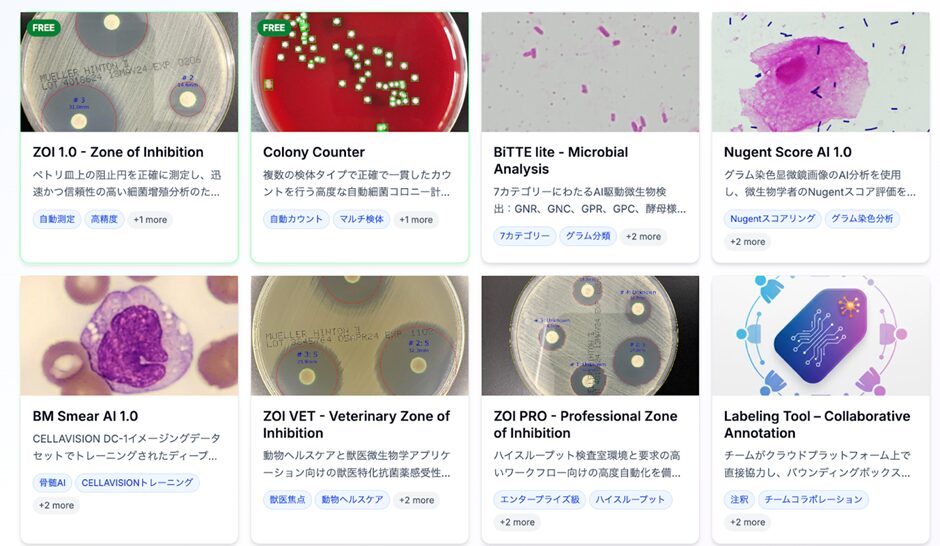

― 組織単位でのDX/AI導入を支援、ライフサイエンス領域への活用を拡大 ―
カーブジェン株式会社(本社:東京都渋谷区、代表取締役:中島正和、以下「当社」)は、クラウドベースAI画像解析プラットフォーム「CarbConnect®」の組織向け新プラットフォーム 「CarbConnect for Organizations」 を正式リリースしたことをお知らせいたします。
これまで研究者や個人単位で利用されてきたCarbConnect®が、今回のアップデートにより、組織ID管理・アクセス制御・チーム共有・API連携・安全なクラウドストレージなどに対応。病院・大学・研究機関・企業など、より大規模で多拠点な環境下での導入を可能にし、研究・開発現場におけるAI活用を包括的に支援します。
▶サービスページはこちら:https://product.panel.carb-connect.com/ja/

CarbConnect®は、ライフサイエンス分野の研究・検査・製造現場における画像解析やAI応用を目的に開発されたクラウドプラットフォームです。
これまでCarbConnect®個人向け版として、個人研究者を中心に利用が拡大してきましたが、昨今の研究開発現場では「チーム単位」「組織単位」でのデータ活用やAI導入ニーズが急増しています。属人的・手作業中心だった解析フローを効率化し、安全性とスケーラビリティを両立する仕組みが求められていました。
こうしたニーズを受け、当社は大規模法人向けのセキュリティ設計とチームコラボレーション機能を備えた新プラットフォーム「CarbConnect for Organizations」を開発。研究開発の上流から下流まで、データ解析・共有・AI開発を統合的に支援する新しい基盤として提供を開始します。
CarbConnect for Organizationsは、病院・大学・研究機関、製薬・バイオ企業などの法人利用に特化したクラウドベースAI画像解析・データ管理プラットフォームです。阻止円測定、Nugentスコア評価、血球分類、グラム染色解析など、ライフサイエンス分野で用いられる多様なAI解析ツールを、安全な共有環境とチームコラボレーション機能のもとで一元的に運用できます。
▶サービスページはこちら:https://product.panel.carb-connect.com/ja/
主な機能は以下の通りです(今後順次追加予定)。
提供形態はクラウドSaaS(月額または年額ライセンス制)で、14日間の無料トライアルを提供しています。
スモールチームや研究グループ向けには、「Basicプラン」月額30,000円(税込)から利用可能です(月毎の請求)。
利用規模や機関形態に応じて、大学・研究機関向けプラン、臨床検査室向けプラン、企業研究開発向けプランなど、複数の料金体系を用意しています。
現在、CarbConnect®個人向け版は10カ国以上・1万人超の登録ユーザーを有しており、幅広い現場でデータ活用とAI導入の促進を支援しています。
当社は今後、CarbConnect for Organizationsを基盤として、食品工場・細胞製造・創薬・化粧品・製造業など、幅広いライフサイエンス領域でのDX/AI実装を加速させてまいります。
また、国際的な研究機関・CRO・病院ネットワークとの連携を通じて、医療・産業・研究の垣根を超えたAIエコシステムの形成を目指します。